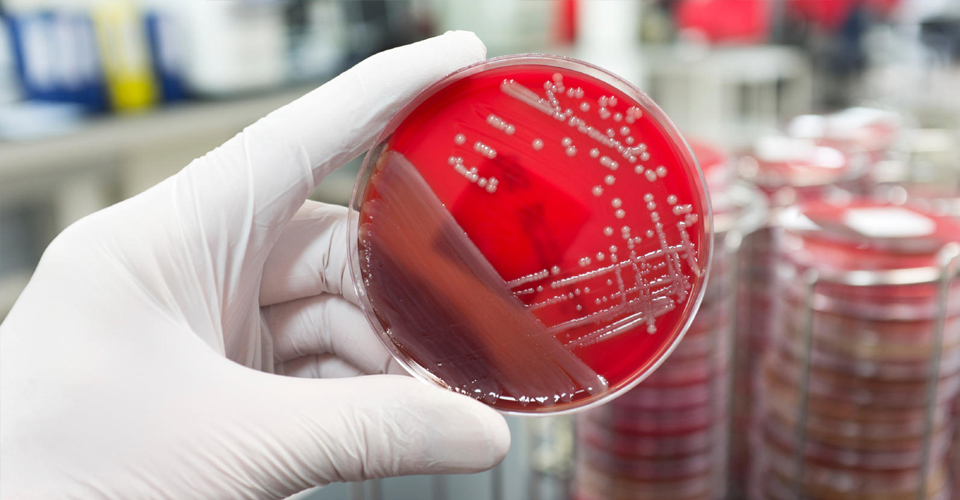

GENOMICS SERVICES
UniBiosys offers genomics services to support
Research Institutes, Life Science Companies and
Scientists working in the areas of Molecular
Biology, Molecular Microbiology, Cell Biology,
Discovery research etc.
1.DNA Barcoding Services
- Microbial Barcoding for bacteria and fungi
- Animal Barcoding for land vertebrates, fishes and seafood
- Plant Barcoding
- Actinomycetes Barcoding
- Insect Barcoding
- Pathogen Identification Services
All analysis are carried out by our ISO 9001:2015 certified
laboratory.
2. Molecular Identification of Prokaryotes and Eukaryotes
3. DNA Fingerprinting Service ( RFLP/ RAPD/ERIC)
4. Genotyping Services
5. Cloning & Sequencing for Amplified Products
6. Primer Designing and synthesizing
7. Gene Expression and SNP Genotyping
8. Microsatellite Discovery and Genotyping
MICROBIOLOGY SERVICES
UniBiosys offers Microbial testing services and analyze products from a wide variety of
industries.
Isolation, culturing and media optimization of microbes
Biochemical evaluation of microorganisms
Metabolite screening and analysis
Antimicrobial Assay etc.
PROTEOMIC SERVICES
Proteomics is a very powerful and promising approach to study proteins involved in various
biological processes.
UniBiosys offers,
Protein analysis
Protein purification and characterization
Extraction and purification of Enzymes
BIOINFORMATICS ANALYSIS

Information gathering and knowledge discovery is the latest
challenge in modern biology. A wide range of research services are offered for the pharmaceutical/
Biotech/ Life science industries.